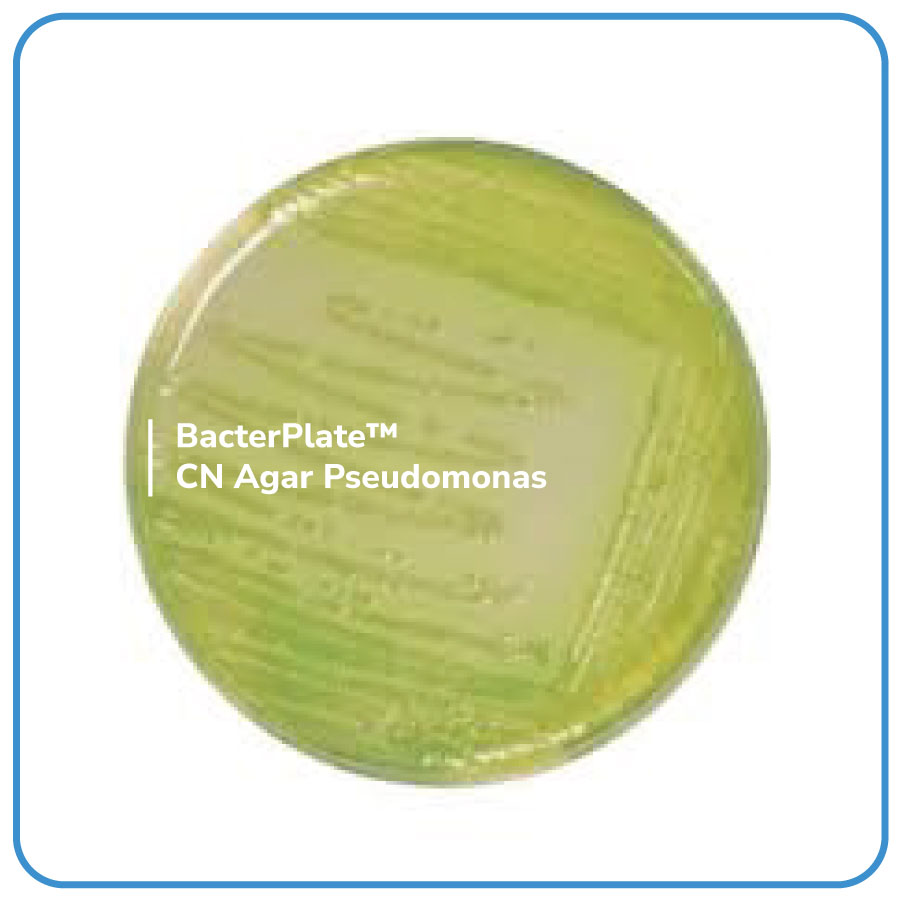

BacterPlate™ CN Agar Pseudomonas là một môi trường chọn lọc để phân lập và định lượng Pseudomonas aeruginosa trong nước đóng chai, bể bơi và nước sinh hoạt.
Mã: 4102029
| Tên sản phẩm | Hình ảnh | Mã đặt hàng/sản phẩm | Đơn vị tính | Số lượng | Chọn vào giỏ hàng |
|---|---|---|---|---|---|
| BacterPlate™ CN Agar Pseudomonas | ![]() | 4102029 | Đĩa |